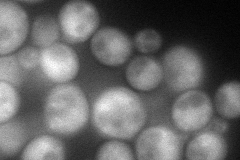
YGR120C
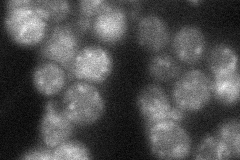
YGR120C
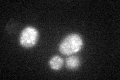
YGR120C
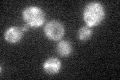
YGR120C
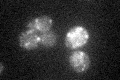
YGR120C

View description
Essential component of the conserved oligomeric Golgi complex (Cog1p through Cog8p), a cytosolic tethering complex that functions in protein trafficking to mediate fusion of transport vesicles to Golgi compartments
Localization:
Intensity:
Fold change:
Significance:
-
C’ GFP library in SD

punctate23.48 -
N' NOP1pr-GFP in SD
cytosol79.3958 -
N' TEF2pr-mCherry in SD

cytosol114.367 -
N' NATIVEpr-GFP in SD
punctate31.4682 -
N' TEF2pr-VC and Cyto-VN in SD

cytosol38.8323 -
C’ GFP library in SD+DTT
punctate24.281.03No -
C’ GFP library in SD+H2O2
punctate19.130.81No -
C’ GFP library in Starvation Media
punctate24.841.05No -
C’ GFP library on the background of Pup2-DaMP

punctate -
C’ GFP library on the background of CCT mutant

punctate19.60560.834674No
